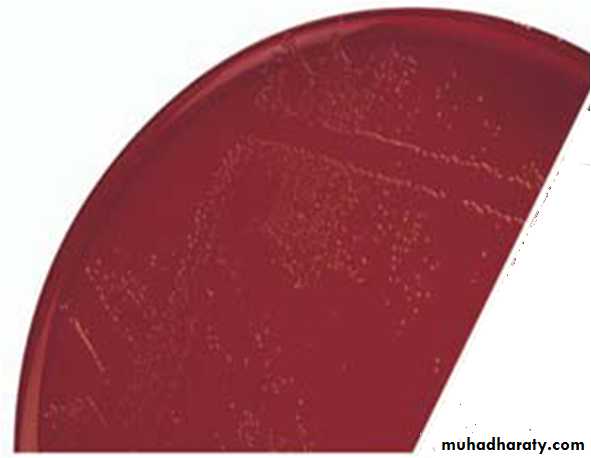
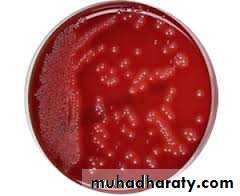

Fastidious Gram Negative Coccobacilli
Presented by:Dr Zena Makki Al-Youzbaky
MsC in Medical Microbiology
1
Fastidious gram negative coccobacilli
Fastidious M.O: M.O that need a complex nutritional requirements for their growthCoccobacilli: M.O is short rods that appear as a cocci
Three genera are included belonging to different families:
1. Genus: Haemophilus
2. Genus: Bordetella
3. Genus: Brucella
2
Genus: Haemophilus
The word Haem means blood, and philus means loving.This m.o. Requires blood for its growth.
Classification:
There are 2 criteria for the classification of these m.o.:
1. Their ability to haemolyse blood.
2. Their requirments for X and/or V factors.
3
Differentiation of Species
• H. haemolyticus• +
• +
• +
• H. Parahaemolyticus
• +
• -
• +
• H. influenzae
• -
• +
• +
• H. aegyptius
• -
• +
• +
• H. ducreyi
• -
• +
• -
• H. parainfluenzae
• -
• -
• +
• H. aphrophilus
• -
• -
• -
Hemolysis
X Y
Growth
Factor
4
Haemophilius influanzae
Previously called Pfeiffer’s bacillus or Bacillus influenza
The bacterium was mistakenly considered to be the cause of influenza until the viral cause of influenza became apparent.
This species was the first free-living organism to have its entire genome sequenced.
two major categories of H. influenza were defined:
The un encapsulated strains
The encapsulated strains.
5
Encapsulated strains were classified on the basis of their distinct capsular antigens by a test called Quellung Reaction which is capsule swelling test. The capsular antigen can be identified by counter current electrophoresis (CCE) and immunofluorescent (IF) test.
There are six generally recognized types of encapsulated H. influenza: a, b, c, d, e, and f.
The most imp spp is Haemophilus influanzae type b (Hib)
6
Microscopical appearance of genus Haemophilus
Gram negative coccobacilli sometimes appear as diplococci .Pleomorphism: From young cultures (6-8 hr.), the m.o. are coccobacilli and capsulated, while from old cultures (18-24 hr), they are long bacilli with filamentous forms and are non-capsultated .
7
Cultural requirements and culture media
Genus Haemophilus needs:Both X and V factors
X-factor ( hemin)
Heat-stable substance
Present in RBC and released with degradation of hemoglobin
V-factor (NAD: nicotinamide adenine dinucleotide)
Heat- labile
Found in blood or secreted by certain organisms
8
Continue cultural requirments
B. Temperature: These m.o. tolerate temperatures of 25 - 40 C, but the optimum is 37 C.C. CO2: These m.o. Require 10% CO2 for their growth which is provided by candle jar.
D. Isovitalex (1%): Added to the culture media can enhance the growth of the m.o.
9
10
Culture Media:
The media used for the cultivation of these m.o. have to contain blood from rabbits or horses and not from human or sheep because it contains anti-Haemophilus antibodies. The most important media used are:• Brain- heart infusion supplemented with blood.
B. Chocolate agar.C. Levinthal’s agar which is nutrient agar supplemented with blood.
Haemophilus influanzae is facultatively anaerobic bacteria.11
Colony morphology:
semi-opaque, gray-white, convex, mucoid.
young cultures they have strong iridescence or some times are described as dew-like colonies, while in old cultures the colonies are rough and not glistening. Also, the growth have a bleach –like or mousy odour. Such odours can be smelled from the mouth of patients when infected with H. influenzae
12
Haemophilus influanzae identification:
1. Gram stainGram negative cocco-baccillus
2. Catalase +
3. Oxidase +
4. X and V factor strips or disks
5. Satellite phenomenon (Satellitism): around the growth of Staphylococcus aureus (in the hemolytic zone) or Strep. pneumoniae or Neisseria gonorrhoeae) the colonies of H. influenzae will be larger. This is because the former growth provides an extra amount of V factor which enhances the size of the Haemophilus colonies.
13
Satellite phenomenon (Satellitism)
14
The antigenic structures (virulence factors):
CapsuleAntiphagocytic
IgA Protease
Cleaves IgA on mucosal surfaces
Lipid A
Effects ciliated respiratory epitheliumPili
Attachment15
Clinical infections of Hib:
Acute epiglottitis or laryngotracheal infection in small childrenCan cause airway obstruction needing immediate tracheostomy
Cellulitis/arthritis
cheek and upper extremities
Meningitis
Children under 6 years
Contagious, vaccine has decreased incidence
Pneumonia/septicemia
In children
Conjunctivitis “pink eye”
very contagious
16
Other haemophilus spp of clinical importance:
H. ducreyi
Sexually transmitted disease - chancroid
H. influenzae biogroup aegyptius
Brazilian Purpuric Fever
H. aegyptius
“pink eye” (purulent conjunctivitis)
H. aphrophilus
pneumonia
Infective endocarditis
17
Diagnosis:
1. Specimens: Nasopharyngeal swabs, pus, blood, and spinal fluid.2. Direct identification; by immunofluorescent (FA), Quellung reaction for capsule swelling test, or commercial kits for identification of H. influenzae antigens in the CSF.
3. Culture (mentioned above).
18
Treatments:
Mortality rate from H. influezae meningitis may reach up to 90%.Many strains of this m.o. are sensitive to ampicillin and 25% of them are beta lactamases producer.
Most strains are susceptible to chloramphenicol. So, combined use of ampicillin and chloramphenicol in the treatment of meningitis is important to prevent neurological complications and intellectual impairment. Moreover, cefotaxime may also give excellent results . Subdural fluid accumulation after meningitis requires surgical drainage.
19
Prevention & Control:
• Haemophilus b conjugate vaccine to children can prevent infections.2. Prophylactic rifampin to exposed nonimmune children under 4 years of age is recommended.
20
TAKE 5!
21
Genus: Bordetella
There are 3 important species of Bordetella:1. B. pertussis.
2. B. Parapertussis.
3. B. Bronchiseptica.
B. pertussis is the causative agent of a highly infectious disease which is called pertussis (whooping cough).
B. parapertussis can cause a disease similar to whooping cough, but often subclinical of mild. It grows more rapidly and produces larger colonies than B. pertussis.
B. bronchisepica is important in canines, produces smaller m.o., and infrequently is responsible for chronic RTI in humans.
22
Bordetella pertussis
Strict aerobe
Gram negative
Small Coccobacillus -singly or in pairs
Transmission by aerosolized droplets
A capsule is present which can be stained by safranin O stain.
Strictly human pathogen
23
• DIFFERENTIATION OF BORDETELLA SPECIES
• Growth on common lab media• ( MacConkey)
• Growth on Bordet-Gengou agar
• Urease
• Oxidase
• Motility
• B. pertussis
• -
• +
• -
• +
• -
• B. parapertussis
• +
• +
• -
• -
• B. bronchiseptica
• +
• +
• +
• +
24
B. pertussis
Small, transparent, gray, convex hemolytic colonies ,look like mercury drops or pearl-appearance on
Bordet-Gengou medium
25
Culture:
Because it is a fastidious m.o, it requires enriched media for its cultivation which are:1. For primary isolation; an enrichment media is used. This medium is called Bordet-Gengou (potato-blood-glycerol agar). The medium contains 20-30 % sheep blood cells and penicillin -G or methicillin to make more selective.
2. Buffered charcoal yeast extract agar (BCYE); this medium can also be used for the isolation of Legionella pneumophila .
3. Blood Charcoal Agar (BCA) to which an antibiotic may be added as cephalexin to make more selective ( inhibits respiratory flora).
4. Lowe-Regan agar which is similar to BCA, but contains a half strength of charcoal.
26
Antigenic structures:
1. Capsule (K-Ag) which is mainly present in phase I and is a virulent factor.2. Pertussis Toxin which is a major virulent factor and has the following effects:
A. It gives a prolonged immunity.
B. It causes anaphylactic –like reaction.
C. It is responsible for the characteristic paroxysmal cough that is followed by deep inspiration .
D. It causes hypoglycaemia.
E. It reduces the migratory and phagocytic activity of macrophages and neutrophils.
F. It can increase the release of both B and T cells from the bone marrow, spleen and L.N→ absolute lymphocytosis
27
Continue…..Ag structures
3. Filamentous haemagglutinin that mediates adhesion to ciliated epithelial cells.
4. Leucocytes promoting factor that promote lymphocytosis.5. Lethal toxin that causes local necrosis.
6. Tracheal cytotoxin which affects the activity of epith. and cilia of respiratory tract.
7. Adenylate cyclase complex that can impair phagocytosis.
28
Pertussis Pathogenesis
Two-stage process of diseaseRespiratory colonization
7-10 days
NO symptoms
Positive cultures toward the end of this stage
Toxin-mediated disease
29
Clinical picture of pertussis disease Whooping Cough
The incubation period of pertussis is about 2 weeks.Two stages parallel to stages of pathogenesis.
1. Catarrhal stage:
This stage coincides with the colonization stage.
Takes about 10 days
Patient suffers from flu-like illness with sneezing and mild cough.
During this stage the patient is very infectious because spraying huge numbers of m.o. through the respiratory tract.
30
2. Paroxysmal stage:
This stages coincides with toxaemic phase .During this stage the patients suffer from the characteristic cough (whooping) which may be associated with vomiting and some times aspiration of the vomitus.
Obstruction of the bronchioles with mucous blugs may lead to the collapse of lung tissues (ateletasis).
Moreover, during this stage the toxic effects of pertussis toxin are manifested as absolute lymphocytosis or hypoglycaemia.
Fatal encephalitis may occur in debilitated (weak) children.
31
Diagnosis:
• Specimens: A saline nasal wash is the preferred specimen.Nasopharyngeal swabs or cough droplets expelled onto a “ cough plate” held in front of the patient’s mouth during a paroxysm are some times used.
2. Direct fluorescent antibody (FA) test to examine nasopharyngeal swab specimens with sensitivity of 50%.
3. Cultures: Mentioned previously.
4. The m.o. can be identified by FA or slide agglutination test with specific antisera.
5. Polymerase chain reaction (PCR): It is the most sensitive method for the diagnosis of pertussis.
6. Serology: Serological tests are of limited value because specific antibodies
( agglutinating or precipitating) rise does not occur until the third week of illness.
32
Treatment:
Antimicrobial drugs: B. pertussis is sensitive to many drugs in vitro. During the catarrhal stage erythromycin promotes the elimination of the m.o. and may have prophylactic value.
Treatment during the paroxysmal stage rarely alters the clinical course.
2. Oxygen inhalation and sedation may prevent anoxic damage to the brain.
33
Prevention:
1. Vaccination (part of DTP): 3 doses in the first year of life, followed by booster of a total of 5 injections.2. New acellular vaccine of 5 antigens is also available.
3. Prophylactic erythromycin for 5 days is given for unimmunized infants or heavily exposed adults.
34
Genus Brucella
Gram –ve coccobacilliNon capsulated
nonmotile
Facultatively intracellular coccobacilli.
Brucella is the cause of brucellosis, which is a zoonotic disease
Brucellosis is also called Undulant fever, Malta fever, Gastric fever, Mediterranean fever.
35
Six species of genus Brucella:
1. B. abortus : cattle2. B. melitensis : sheep and goat
3. B. suis : pig
4. B. canis : Dog
5. B. ovis : Sheep
6. B. neotomae : Desert wood rat
36
Culture media
1. Trypticase soy agar.2. Castaneda biphasic medium (broth & agar). This medium is prepared in bottles and has two portions; solid one (bottom), and liquid (top). The m.o. can grow on the surface of the solid portion and in the liquid rendering it turbid.
3. Blood agar & blood culture media.
4. MacConkey’s agar supplemented with 5% of heated horse or rabbit serum.
5. Brucella selective medium .
6. Thionine tryptose agar.
37
38
Cultural characterestics
On blood agar Brucella appear small, moist, transparent, glistining , slightly yellowish in young cultures but brownish in old ones, and appear in 2- 5 days (may be delayed up to 3 weeks).B. abortus requires 5-10% CO2 for growth, whereas the other species grow in air.
Fresh specimens from animals or human sources are usually inoculated on trypticase-soy agar or blood culture media.
39
Clinical Picture of Brucellosis
Incubation period : 1-6 wksMethods of transmission: ingestion of milk or milk product (unpasteurized), direct contact with infected animals( abrasion of skin) .
Insidious onset
Headache, malaise, GIT symptoms.
undulant fever: usually rises in the afternoon; its fall during the night is accompanied by drenching sweating.
L.N. enlarge, and the spleen becomes palpable.
Hepatitis may be accompanied by jaundice.
Following the initial infection, a chronic stage may develop; characterized by weakness, aches and pains, low grade fever, difficult to diagnose.
40
Diagnostic Laboratory Tests
A. Specimens: Blood and biopsy materialB. Culture: Mentioned above.
C. Serology:
IgM antibody levels rise during the FIRST week of acute illness, peak at 3 months, and may persist during chronic disease. Even with appropriate treatment, high IgM may persist up to 2 years.
IgG antibody levels rise 3 weeks after onset of acute disease, peak at 6- 8 weeks and remain high during chronic disease.
IgA levels parallel the IgG levels; could be blocking antibody (causes prozone pheno.).
41
42
Serological test Dx of brucellosis
1. Serum Agglutination test (SAT) (tube or slide); using:a. Standerized brucella antigens.
b. Rose Bengal antigens (stained red).
The significant titer = 1/160 or higher or
Four fold increase 2 weeks a part
False positive: Cross reaction may occur with cholera vaccine, S.typhi /paratyphi , or Yersinia.
False negative : Pozon phenomena
2. 2-Mercaptoethanol test; 2-ME can destroy IgM and leaves IgG. This may be used to differentiate between chronic and active brucellosis.
43
Continue
3. Blocking antibodies;These are IgA antibodies that interfere with agglutination by IgG & IgM and cause false negative result (prozone phenomena). These antibodies appear during the subacute stage of infection tend to persist for many years, and are detected by Coomb’s antiglobulin method. Also, high dilution agglutination test can overcome the problem of prozone phenomena.
4. Skin test (Brucellergen or Brucellin
5. ELISA , RIA or Immunofluorescent ; for Ab detection.44
Treatment:
Combined anti-microbial drugs are used, taking in consideration that the m.o. is an intracellular one:1. Refampin with doxycycline gives 97% cure rate. Also, an aminoglycoside drug could be added.
Treatment should be continued for at least 6 weeks and for bone or joint infections the treatment continues for at least 8 weeks.
For neuro-Brucellosis chloramphenicol or ampicillin could be used with other drugs.
45
Prevention
Immunization of animals.Pasteurization of milk and milk products
No human vaccine
46
47